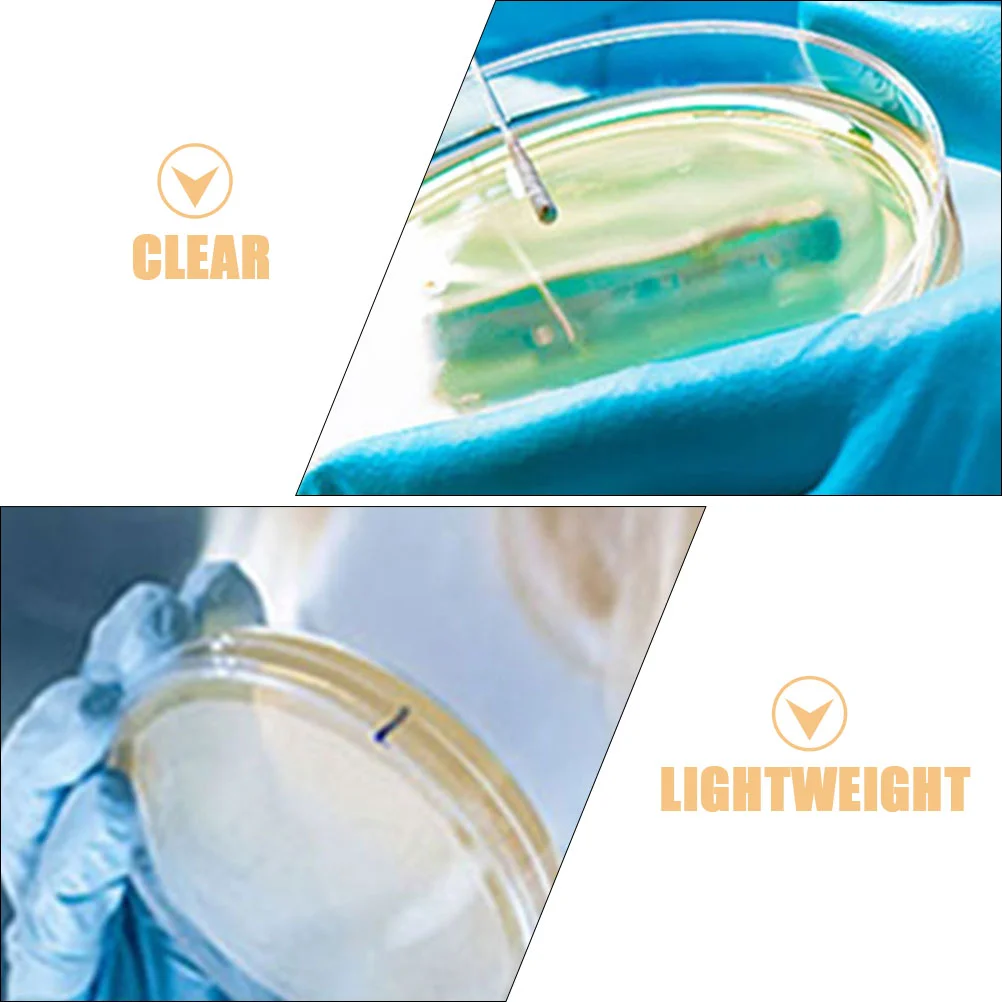
thumb

10 шт., чаши Петри, лабораторные тарелки Петри для анализа, прозрачные чаши Петри, принадлежности для проектов (100 мм)
Price history chart & currency exchange rate
Customers also viewed

$2.18
Repair Tools Strong Clamping Small Medium Large Bass Violin Front Back Plate Bonding Jigs Clamps Guitar Clamp
aliexpress.com
$1.51
Practical Erhu Tuner for Violin Cello High Sensitivity Metal Accessories Adjuster Accurate Portable Musical Instrument
aliexpress.com
$9.70
45G Toner Powder Dust Refill Kits FOR Brother MFC 9325CW DCP9010CN HL3040CN HL3070CW MFC9010CN MFC9120CN MFC9320CW HL3045CN
aliexpress.ru
$1.24
2/5/10m High Temperature Resistant Silicone Copper Wire 300°C Warm Floor Heat Element Line Fiberglass Braided Cable
aliexpress.ru
$70.82
New Style PVC Waterproof Mens Rain Shoes Outdoor Fishing Boots Wading Shoes Stretch Breathable Camouflage High Tube Rain Boots
aliexpress.ru
$10.99
Star Shaped Sunglasses Women, Vintage Bling Rhinestone Pentagon Sun Glasses Retro Shades Glasses Dance/Party/Halloween
aliexpress.ru
$18.93
Подвески в виде Санта Клауса, Рождественское украшение, снеговик, дерево, искусственное светодиодное украшение для скалолазания, украшение для дома и улицы
aliexpress.ru
$66.59
long dress runway summer women short sleeve printed belt chic vintage elegant casual party pleated fashion 210421, Black;gray
dhgate.com
$33.54
women s shorts weird puss hairy side split women zebra print skinny lace up 2023 fashion wild casual streetwear elastic mini bottoms 230308, White;black
dhgate.com
$39.10
Для Porsche Macan Cayenne Panamera 718 911 Красный Алькантара рукоятка переключения крышка Шестерни подшипники аксессуары
aliexpress.ru
$1.41
12inch /13inch /14inch /16inch Bar Stool Cover Round Chair Seat Cover Sleeve Elastic Fabric
aliexpress.com
$74.70
Retractable Stool Folding Chiar Outdoor Portable Stool Folding Chair Camping Stool Convenient Fishing Foldable plastic stool
aliexpress.com
$33.40
22ss fashion designer mens hoodie couples pullover street fashion hip hop sweater loose long sleeves sweatshirts ladies white sweatshirt, Black
dhgate.com
$14.91
Swimwear Bikini Cover Up Hollow Out Crochet Patchwork Summer Loosefitting Sun Protection Swimwear Tunic for Beach, Black
dhgate.com
$7.61
Plus Size Ruffle Blouse Women Summer Leopard Print Splicing Tunics V-neck Short Sleeves Casual T Shirt Blusas 2022
aliexpress.com
$1.81
Clothes Heating Mat USB Charging Durable Wide Application Small Fast 5V 2A Heating Pad
aliexpress.com
$46.33
мужская zoom pegasus 36 trail роскошь дизайнер кроссовок 36xfly поколение pegasus жаккардовых спортивные тренажеры мужчина плоские кроссовки
dhgate.com
$54.87
meeshow slim reading glasses women cat glasses with alumiun case metal pocked presbyopia glasses +2.25+1.75 +3.5 r1004
dhgate.com
$2.28
Peppa pig pretend play children's kitchen toys baby cooking cooking utensils tableware gifts Toy for children
aliexpress.com
$30.86
brand new summer women fashion 11cm super high sandals buckle strap thin heels sandals peep toe party, Black
dhgate.com